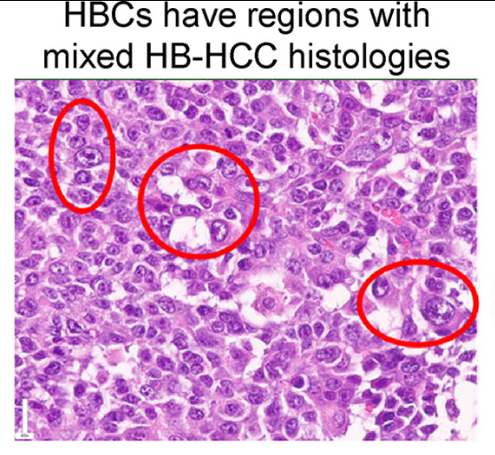

Study reveals how a rare pediatric liver cancer emerges
Liver cancer in children is rare, but when it occurs the two main types are hepatoblastoma (HB) and hepatocellular carcinoma (HCC). In some cases, however, the tumors show features of both types. These tumors have been classified into a third tumor category called hepatoblastoma with carcinoma features (HBC).
There are many unanswered questions about tumors in this category, but in a current study published in the Journal of Hepatology, researchers at Baylor College of Medicine, Texas Children’s Hospital and collaborating institutions reveal valuable insights into HBC’s cellular composition and the relationships between different cell types in the tumors. The findings have implications for the tumors’ response to therapies and understanding how HBC tumors emerge.
“In 2022, our team identified HBCs as a third group of liver tumor types in children,” said co-corresponding author Dr. Pavel Sumazin, professor of pediatrics, hematology-oncology at Baylor. Sumazin also is a member of the Dan L Duncan Comprehensive Cancer Center and Quantitative and Computational Biosciences at Baylor.
In the current study, we applied multiple genetic profiling techniques to characterize the composition of 42 HBCs, mapping out the origins of the different cell types and their responses to treatment.”
Using DNA and RNA single-cell sequencing – a technique to study thousands of tumor cells one at a time – the researchers discovered that HBC tumors contain three kinds of cancer cells: HB-like cells, HCC-like cells and HBC-specific cells, which show molecular features of both HBs and HCCs. “HBCs originate from hepatic stem cells and these types of undifferentiated tumor cells are less responsive to chemotherapy and immunotherapy,” Sumazin said.
Analyzing treatment outcome data from 41 patients revealed that children with HBC tumors had worse survival rates than children with typical HB. “The 5-year overall survival is about 80% for HB patients and around 40% for HBC patients overall, but transplanted HBC patients do better,” Sumazin said. “This significant difference underscores the importance of understanding what makes HBC tumors so resistant to treatment.”
When the team investigated the relationships between the different molecular cell types in HBC tumors, they discovered that HBC cells originate from HB progenitors and can transition toward HCC, highlighting a molecular continuum between HB and HCC.
“These transitions (HB → HBC → HCC) occur during early embryonic stages of liver development,” Sumazin said. “HBC tumors tend to be composed of cells that have undergone differentiation arrest and retain molecular and other characteristic features of early hepatic stem cells.”
These HB → HBC → HCC transitions occur when the WNT signaling pathway malfunctions. “This pathway plays a crucial role early in normal liver development: it is very active in stem cells then it typically quiets down to allow for cells to differentiate,” Sumazin said. “But in all HBC tumors, WNT stays active and prevents cells from developing normally. Inhibiting WNT signaling promoted cell differentiation and enhanced sensitivity to chemotherapy.”
The study shows that the process that leads to HBC tumors is dynamic and involves multiple HB-to-HBC and HBC-to-HCC transitions. “We showed that HBCs do not arise from a single progenitor cell but instead descend from multiple HB cells that independently undergo tumor-type transitions into HBC.”
Together, these findings provide a new developmental model of pediatric liver cancer, linking sustained WNT signaling during early liver development to tumor heterogeneity, tumor-type transitions and patient outcomes.
For a complete list of all the contributors to this work and their affiliations, see the publication.
This work was partially supported by the European Union Horizon (2020 award H2020-826121), the Cancer Prevention and Research Institute of Texas (awards RP180674, RP190160, RP250580, and RP230120), the National Institutes of Health (awards S10OD032189, P30CA125123, R01CA258866, R01CA282467, R21CA286257, T32GM136554, and UH3CA271227), the Single Cell Genomics Core and the Helis Research Program by the Helis Medical Research Foundation.
Follow From the Labs on X, BlueSky and Instagram!
